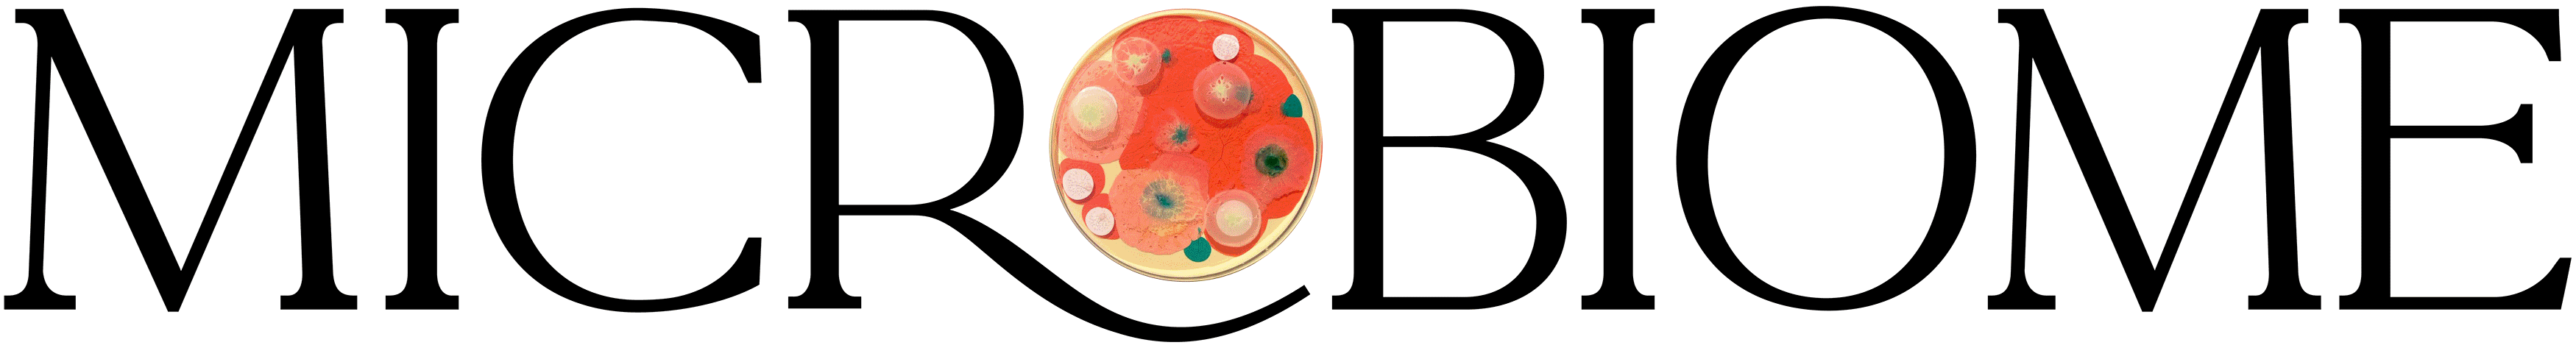

-
 POTENT INGREDIENTS
POTENT INGREDIENTS
-
 DOCTOR-APPROVED
DOCTOR-APPROVED
-
 30-DAY MONEY-BACK GUARANTEE
30-DAY MONEY-BACK GUARANTEE



Mikrobiom
Our Experts Have Been Featured In:

What People Are Saying












THE MICROBIOME SERIES
Detect The Warning Signs Of A Damaged Microbiome… Before It’s Too Late
Did you know that an imbalanced gut microbiome can be the root cause of 90% of all health issues today like:

- Anxiety
- Constipation or Diarrhea
- Acne, Eczema, or Rashes
- Type 2 Diabetes
- Obesity
- Autism
- Dementia & Alzheimer's
- Parkinson's or Tremors
- A Poor Immune System
- Bloating + IBS
- Brain Fog
- Low Energy
- Depression
- Autoimmune Disease
- Heart Disease
- Arthritis
To find answers and bring healing, you need to target your gut microbiome!
Microbiome is an 10-part masterclass that will show you the exact protocols to heal your gut and help prevent disease – no matter your age.
More than 27+ world-leading gut health experts will break down the latest science in this field, sharing the simple yet powerful steps that can help you live a longer, happier life.
MEET THE EXPERTS
The Microbiome Masterclass’ 27+ Experts, Doctors & Researchers

Dr. Catherine Clinton

Dr. Christina Miller

Dr. Cyrus Khambatta

Dr. Darryl Gioffre

Dr. David Perlmutter

Dr. Dr. Elena Ivanina

Dr. Felice Gersh

Dr. Fred Harvey

Dr. Gerry Curatola

Dr. Ilana Gurevich

Dr. Hana Kahleova

Dr. Jason Hawrelak

Dr. Joel Fuhrman

Kiran Krishnan

Dr. Liz Lipski

Dr. Mary Pardee

Dr. Maura Henninger

Dr. Nirala Jacobi

Ocean Robbins

Dr. Peter Bongiorno

Dr. Peter Kan

Dr. Ritamarie Loscalzo

Dr. Vincent Esposito

Dr. Wendy Romig

Dr. Will Bulsiewicz

Dr. Will Cole

Dr. Sarina Pasricha

Meet Your Host
Sarah Otto, Goodness Lover Co-Founder, Nutritionist
Sarah is the producer and host of Microbiome.She was motivated to create this groundbreaking series after she overcame her own struggles with autoimmune disease and chronic fatigue by restoring her gut. She is passionate about sharing the little-known tools that heal guts and change lives.
Course Preview
Microbiome is an 10-part masterclass that will show you the exact protocols to heal your gut and help prevent disease – no matter your age.
You'll receive:
- Episode 1 — The Microbiome Solution: Discover Where Better Health Begins
- Episode 2 — The Autoimmune Solution: Overcome Leaky Gut & Food Sensitivities
- Episode 3 — Conquer Constipation, Reflux & IBS with Probiotics & Fermented Foods
- Episode 4 — Unlock the Power of the Vagus Nerve to Beat Anxiety, Depression & Stress
- Episode 5 — Say Goodbye to Gas & Bloating with Natural Solutions for SIBO & Candida
- Episode 6 — How to Detox Your Gut & Reclaim Your Health
- Episode 7 — Strengthen Your Immune System With Solutions For Infections, Parasites & Histamine Sensitivity
- Episode 8 — Microbiome Mastery & The Longevity Diet
- Bonus Episode 9 — Beat Sleep Challenges & Boost Your Energy
- Bonus Episode 10 — Microbiome Skin Care: Revealing The Gut-Skin Solution
Read at your own pace to gain a deeper understanding and reinforce important concepts.
Listen to the audio format of each and every episode (including the bonus sessions!) so you can learn on the go.
When you choose to own the series today, you’ll be totally taken care of with our step-by-step support! You’ll receive 10 PDFs that neatly summarize the main points of each episode.
We also included the protocols that you can follow weekly or at your own pace—whichever you feel comfortable to do!
Each of the 10 protocols has been carefully crafted to help you create your own personalized gut-restoring blueprint, so you can feel safe, secure, and supported on your journey to healing.
You’ll learn what action steps to take and when, what to eat, what to avoid, the right way to detox your body, which natural remedies actually work, how to stimulate your vagus nerve, and how to sleep better… plus so much more!

Episode 1: The Microbiome Solution: Discover Where Better Health Begins
- The subtle symptoms of gut imbalances (and how small irritations can snowball into big problems)
- What causes problems in the microbiome - and the everyday steps you can take to prevent them
- The #1 most important nutrient for maintaining health and preventing disease (and what it means for the 95% of us who aren’t getting enough)
- The best supplement to support the gut - especially for people who can’t tolerate a broad diversity of plant foods

Episode 2: The Autoimmune Solution: Overcome Leaky Gut & Food Sensitivities
- The relationship between leaky gut and the development of autoimmune diseases
- What causes a leaky gut in the first place? Find out if there’s a part of your lifestyle that’s unknowingly damaging your gut
- All-natural ways to heal your gut lining — from the right foods to eat to easy lifestyle changes to the right supplements and herbs
- The doctor-approved protocols to overcome food sensitivities, especially if you cannot tolerate some healthy foods like broccoli or beans

Episode 3: Conquer Constipation, Reflux & IBS with Probiotics & Fermented Foods
- What your poop is trying to tell you (and find out what your bowel movements reveal about your health status)
- The 5 steps to picking the right probiotic according to a microbiome research expert
- The constipation relief technique the internet can’t stop talking about (and learn how to perform the viral “internal shower”)
- The best fermented foods you can eat today to boost beneficial gut bacteria

Episode 4: Unlock the Power of the Vagus Nerve to Beat Anxiety, Depression & Stress
- What exactly is the gut-brain connection (+plus natural remedies for anxiety, depression, and stress)
- The link between brain disorders and bad gut bacteria (like dementia, cognitive function, Alzheimer's, and Parkinson's)
- How to unlock the power of your vagus nerve for better mental health
- An emerging new treatment that introduces good bacteria into your gut—fast
- How a popular and easily prescribed anti-inflammatory medication can wreak havoc on your gut (plus holistic alternatives that work just as well without hurting your gut)

Episode 5: Say Goodbye to Gas & Bloating with Natural Solutions for SIBO & Candida
- Why we need to take bloating seriously (and how you can put an end to this painful and embarrassing symptom)
- The ancient Ayurvedic remedy for constipation and bloating that is still used to this day (and learn how to use it to improve your digestion)
- The herbal treatments for bacterial overgrowth that are proven to be just as effective as antibiotics
- How to recognise the subtle signs of excess Candida (+plus discover potent herbal remedies for fungal overgrowths)

Episode 6: How to Detox Your Gut & Reclaim Your Health
- The role your gut plays in keeping your body’s detoxification process running
- How to recognise the symptoms of toxin exposure that often get confused with other conditions
- A stealth pathogen in your home that could be silently affecting the brain and nervous system without you knowing
- A unique probiotic that prevents harmful metals like lead, arsenic, and cadmium from getting into your cells
- The critical first step to detoxification that most people miss

Episode 7: Strengthen Your Immune System with Solutions for Infections, Parasites & Histamine Sensitivity
- The real reason some infections never seem to go away (+plus discover the key to restoring your immune system and getting your energy back)
- How a parasite could be draining your energy – even if you think you haven’t been exposed – and discover the herbal treatments that actually work
- Biofilms – the “communities” of bacteria and viruses that make themselves at home in your body – and how they disrupt your health (did you know they can “vote”?)
- Learn about herbal remedies for quelling histamine flare ups and the #1 thing most people do wrong when it comes to natural treatments for histamine intolerance

Episode 8: Microbiome Mastery & The Longevity Diet
- How people who stay healthy into their 90s (and beyond!) supercharge their microbiome to prolong their years of health and happiness
- The best—and worst—foods for your gut (including a popular diet that wreaks havoc on the microbiome)
- The one thing that can restore your microbiome in just 3 days (according to researchers at Harvard University)
- How to elevate common foods to superfood status with simple (and time-saving!) meal prep magic
- The foods that help you lose more weight the more you eat (and they’re good for your gut, too!)

Episode 9 (Bonus): Beat Sleep Challenges & Boost Your Energy
- Discover how your sleep schedule impacts your microbiome and find out what time you need to be in bed in order to have a healthy gut
- Learn how to harness the power of the sun to have more energy, better focus, and a healthier gut
- Find out which common bedtime routine can actually make it a lot harder to fall asleep and learn more reliable strategies for winding down
- Discover gentle herbal remedies that safely help you fall asleep and stay asleep
- Discover the one mealtime strategy that is proven to make people live longer and learn how to make it work for you

Episode 10 (Bonus): Microbiome Skin Care: Revealing The Gut-Skin Solution
- Find out how to tell if your acne, eczema, or rosacea is actually a symptom of a gut problem and learn how to soothe and restore your skin
- Find out why you might want to think twice about taking antibiotics for skin breakouts and learn about the probiotic that reduces acne by 70%
- Discover herbal remedies that work just as well as antibiotics, without any of the negative side effects
- Discover the amazing world of the soil microbiome and learn how to improve your health by spending more time outside

PDF Transcripts
Read at your own pace to gain a deeper understanding and reinforce important concepts.

MP3 Audio Downloads
Listen to the audio format of each and every episode (including the bonus sessions!) so you can learn on the go.
STEP-BY-STEP GUIDANCE
Episode Summaries & Protocols
When you choose to own the series today, you’ll be totally taken care of with our step-by-step support! You’ll receive 10 PDFs that neatly summarize the main points of each episode.
We also included the protocols that you can follow weekly or at your own pace—whichever you feel comfortable to do!
Each of the 10 protocols has been carefully crafted to help you create your own personalized gut-restoring blueprint, so you can feel safe, secure, and supported on your journey to healing.
You’ll learn what action steps to take and when, what to eat, what to avoid, the right way to detox your body, which natural remedies actually work, how to stimulate your vagus nerve, and how to sleep better… plus so much more!

This takes the guesswork out of knowing how to implement your new knowledge into your daily life – and saves you time and headache trying to figure which step to take next.
We know there’s a lot of confusion and misinformation out there about how to manage your health effectively. And we’d never give you all this information and then leave you to figure it all out on your own. Your life is full enough already!
Instead, you’ll be guided through each episode, one step at a time, all from the comfort of your own home. You can follow every week or take it as slow as you’re comfortable doing – it’s totally up to you!




You're Protected By Our 30-Day Guarantee
The Microbiome program comes with a 30-day guarantee.
If you’re not over-the-moon thrilled with your experience, simply send us an email to start the refund process. It’s that simple!





